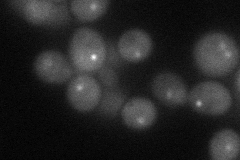
YIR010W
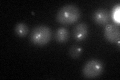
YIR010W

View description
Essential component of the MIND kinetochore complex (Mtw1p Including Nnf1p-Nsl1p-Dsn1p) which joins kinetochore subunits contacting DNA to those contacting microtubules; important for chromosome segregation
Localization:
Intensity:
Fold change:
Significance:
-
C’ GFP library in SD

punctate19.97 -
N' NOP1pr-GFP in SD

punctate37.4707 -
N' TEF2pr-mCherry in SD
punctate40.8304 -
N' NATIVEpr-GFP in SD

below threshold17.809 -
N' TEF2pr-VC and Cyto-VN in SD

#N/A0 -
C’ GFP library in SD+DTT
punctate23.071.15No -
C’ GFP library in SD+H2O2

punctate17.590.88No -
C’ GFP library in Starvation Media

punctate19.250.96No -
C’ GFP library on the background of Pup2-DaMP

punctate -
C’ GFP library on the background of CCT mutant

punctate21.83481.09274No
